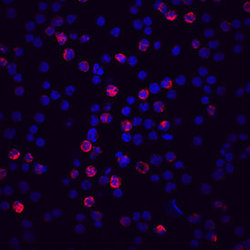

Antibody data
- Antibody Data
- Antigen structure
- References [0]
- Comments [0]
- Validations
- Western blot [1]
- Immunocytochemistry [1]
- Flow cytometry [1]
Submit
Validation data
Reference
Comment
Report error
- Product number
- ABIN4899500 - Provider product page

- Provider
- antibodies-online
- Product name
- anti-Complement Factor H-Related 4 (CFHR4) (AA 20-331) antibody
- Antibody type
- Monoclonal
- Description
- Protein A or G purified from hybridoma culture supernatant
- Reactivity
- Human
- Host
- Mouse
- Epitope
- AA 20-331
- Isotype
- IgG
- Antibody clone number
- 640212
- Vial size
- 100 μg
- Storage
- Use a manual defrost freezer and avoid repeated freeze-thaw cycles. 12 months from date of receipt,-20°C to -70°C as supplied. 1 month,2°C to 8°C under sterile conditions after reconstitution. 6 months,-20°C to -70°C under sterile conditions after reconstitution.
No comments: Submit comment
Supportive validation
- Submitted by
- antibodies-online (provider)
- Main image

- Experimental details
- WB
Supportive validation
- Submitted by
- antibodies-online (provider)
- Main image
- Experimental details
- ICC
Supportive validation
- Submitted by
- antibodies-online (provider)
- Main image

- Experimental details
- FACS